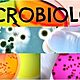
Microbiologia 665x285

-
Se ha asociado con la invención del microscopio de un solo lente (simple) y del compuesto (de dos o más lentes).
-
Janssen se ha asociado con la invención del microscopio de un solo lente (simple) y del compuesto (de dos o más lentes).
-
Fue el primero en refutar la teoría de la generación espontanea en gusanos.
-
Es el primero en observar bacterias o ani malculos
-
Es el primero en observar bacterias o ani malculos
-
Desarrolla la primera vacuna contra la viruela humana.
-
Realiza el primer estudio epidemiologico del cólera en londres.
-
Se hizo famoso por descubrir el bacilo de la tuberculosis.
-
Inicialmente se dedicó al estudio de la bacteriología descubriendo la Escherichia coli.
-
Demuestran que el Treponema pallidum es el agente productor de la sífilis.
-
descubre la Penicilina. La penicilina es un antibiótico presente en nuestra sociedad.
-
llevan a cabo el aislamiento e identificación del virus del sida.
-
Se descubre la bacteria gigante Thiomargarita namibiensis.
-
Se secuencia el genoma del Saccharopolyspora erythraea, el microorganismo productor del antibiótico eritromicina.
Want to make a timeline like this?
Use Timetoast to turn dates, events, milestones, and phases into a clear visual timeline you can build and share. Timetoast is a timeline maker for work, school, research, and stories.